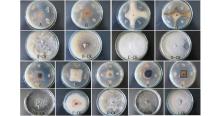

作者简介:荆卓琼(1984-),女,甘肃徽县人,助理研究员,硕士。E-mail: jingzhuoqiong@qq.com
采用平板对峙法,从银杏组织分离的内生细菌菌株中筛选对灰葡萄孢菌抑菌活性较好的菌株,其中菌株HZ-6-3的抑制作用最强,抑制率为79.06%。通过菌落形态观察、生理生化特征、16S rRNA基因序列和 gyrA基因分析将菌株HZ-6-3鉴定为解淀粉芽孢杆菌。抑菌谱测定结果显示,该菌株对其他8种植物病原真菌均具有不同程度的拮抗作用。该菌株可产生蛋白酶、果胶酶、β-1,3-葡聚糖酶和淀粉酶;能够显著抑制病原菌的菌丝生长,使菌丝生长扭曲,细胞膨大、形成串状泡囊结构等畸变。利用盆栽试验测定了该菌株对番茄灰霉病的防控效果,结果显示1×108 CFU·mL-1的预防效果和治疗效果最高,可达81.12%和70.45%。上述结果显示菌株HZ-6-3具有作为生物制剂的潜能。
Bacterial strains exhibiting antifungal activity against Botrytis cinerea, which causes tomato gray mold, were screened from endophytic bacterial strains isolated from tissue of Ginkgo biloba by dual culture. The strain HZ-6-3 showed strong antagonistic activity against B. cinerea with an inhibition efficiency of 79.06%. Based on cultural and morphological characterization, physiological and biochemical characteristics, 16S rRNA gene sequence and gyrA gene sequence, strain HZ-6-3 was identified as Bacillus amyloliquefaciens. The results of antimicrobial spectrum determination showed that strain HZ-6-3 inhibited the growth of eight plant pathogenic fungal species. It could produce proteinase, pectinase, β-1,3-glucanase and amylase. The strain HZ-6-3 exhibited a strong antagonistic activity, resulting in abnormal mycelial growth of pathogenic fungi, including twist, cell-expansion and bubble deformation structures. The efficiency of strain HZ-6-3 for prevention and control of gray mold in tomato plant was evaluated by pot experiment. An application of 1×108 CFU·mL-1 was highly effective against gray mold, and which showed a prevention efficiency of 81.12% and a control efficiency of 70.45%, respectively. These results indicate that B. amyloliquefaciens strain HZ-6-3 may have potential as biological control agent.
番茄灰霉病是由半知菌亚门的灰葡萄孢菌(Botrytis cinerea)引起的一种重要的世界性番茄(Solanum lycopersicum)病害。发病严重时造成减产减收, 甚至绝收[1]。该病害在全国各地普遍发生, 且呈上升趋势, 已成为番茄生产和储藏中的主要限制因素[2]。长期以来防治番茄灰霉病的方法主要是大量施用化学农药和选育抗病品种, 但是灰霉病菌繁殖快、变异度大等特点使得化学药剂极易产生抗药性, 加之品种的抗病程度不高、人们对抗药性及食品安全问题的认识提高等, 使得利用生物防控防治灰霉病菌的需求迫切[3]。
目前用于防治番茄灰霉病菌的生防细菌有10种以上, 芽孢杆菌属(Bacillus spp.)因其产生抗逆性强的芽孢和抗菌物质, 并具有繁殖速度快等众多优点, 成了筛选番茄灰霉病菌拮抗菌的重要来源。其中, 解淀粉芽孢杆菌(B. amyloliquefaciens)是与枯草芽孢杆菌亲缘性很高的细菌, 在自然界中分布广泛, 其生长过程中可以产生一系列具有广泛抑制真菌和细菌活性的代谢产物[4], 而且可以作为天然防腐剂抑制食物腐败, 它已成为具有生物农药开发潜力的微生物。Zhang等[5]从大豆(Glycine max)根部分离到一株内生解淀粉芽孢杆菌能够产生抗菌蛋白和脂肽类抗生素等多种抗菌物质, 对包括番茄灰霉病菌等的10多种植物病原真菌具有很好的拮抗作用, 同时可提高植株的抗病能力; 陈哲等[6]筛选出两株解淀粉芽孢杆菌CM3和Y-48对盆栽番茄灰霉病的防效为65.58%和72.13%; 李红晓等[7]明确了MH71菌株是广谱性高具有高效拮抗活性的解淀粉芽孢杆菌, 高效液相色谱检测结果表明该菌的抗菌物质中存在表面活性素surfactin; 王俊丽等[8]从青岛黄海海域采集的海泥中分离得到了1株具有较高拮抗活性的菌株解淀粉芽孢杆菌QD-10, 在人工接种后第7和11 天, 菌株QD-10的发酵原液处理的防效均为100%; 目前, 人们从解淀粉芽孢杆菌中分离到的环装细菌素(amylocyclicin)[9]、细菌素(bacteriocin)、脂肽类粗提物[10]、抗菌蛋白[11]等抑菌活性物质能较好抑制多种真菌和细菌, 因此较强的抑菌性和广谱性增加了对解淀粉芽孢杆菌的研究价值, 使其成为近年来的研究热点。
银杏(Ginkgo biloba)是银杏属现存的唯一种, 是我国特有的世界名贵树种, 是远古遗留的孑遗植物, 鲜见感染病虫害发生, 其内生微生物必然存在独特性。目前, 已从银杏分离获得多种内生菌, 并从这些内生菌中筛选出具有抑菌活性的菌株。杨瑞先等[12, 13]、范晓静等[14]、李长根等[15]分别从银杏组织内部分离得到内生解淀粉芽孢杆菌, 对辣椒疫霉菌(Phytophthora capsici)、萝卜软腐菌(Pectobacterium carotovorum subsp. carotovorum)和林木变色真菌都有较好防效。
因此本研究从银杏组织中分离并筛选出了1株对番茄灰霉病菌有较强拮抗作用的内生细菌HZ-6-3, 研究了该菌株的形态和生理生化特征, 利用16S rRNA和gyrA基因序列对该菌株进行了鉴定, 并对其抑菌谱进行检测; 通过检测胞外酶活性, 研究了该菌对番茄灰霉病菌和其他常见8种病原真菌菌丝生长的影响, 并对其盆栽防治效果进行初步研究。
2015年7-8月, 银杏样本分别采集于甘肃省陇南市嘉陵镇林区(海拔1221 m, 33° 39'29″ N, 106° 17'6″ E)和甘肃省兰州市甘肃农业大学校区内(海拔1530 m, 36° 5'58″ N, 103° 41'17″ E)。供试番茄灰霉病病菌和用于抑菌谱测定的其他常见植物病原菌均由本实验室分离和保存。
PDA培养基:马铃薯200 g, 葡萄糖15 g, 琼脂15 g, 水1000 mL, 自然pH值。NA培养基:牛肉膏3 g, 酵母浸膏1 g, 蛋白胨5 g, 葡萄糖10 g, 琼脂15 g, 水1000 mL, pH自然。蛋白酶检测培养基[16]:酪蛋白5 g、酵母膏2.5 g、葡萄糖1 g、琼脂18 g、蒸馏水900 mL、7%脱脂牛奶100 mL。淀粉酶检测培养基[17]:蛋白胨5 g、牛肉浸膏3 g、可溶性淀粉10 g、琼脂18 g、蒸馏水1000 mL。果胶酶检测培养基[17]:NaNO3 1 g、K2HPO4 1 g、 KCl 1 g、MgSO4 0.5 g、酵母膏0.5 g、葡萄糖1 g、蒸馏水1000 mL、琼脂18 g、1%果胶。β -1, 3-葡聚糖酶检测培养基[16]:酪蛋白5 g、酵母膏2.5 g、葡萄糖1 g、琼脂18 g、1%羧甲基纤维素、蒸馏水1000 mL。
1.3.1 银杏茎、叶内生细菌的分离纯化 将甘肃兰州市和陇南市的健康银杏叶片和茎用清水冲洗干净、晾干待用; 随机称取样品各5 g, 用75%酒精浸泡1 min后用无菌水冲洗3遍, 再用5%次氯酸钠表面消毒, 叶片消毒5 min, 茎消毒10 min, 无菌水冲洗3遍。用组织印记法检测供试材料表面消毒是否彻底, 将消毒后的银杏组织放置在NA平板上, 培养48 h后观察有无菌落产生。将消毒后的叶片组织放入无菌研钵中, 加10 mL无菌水研磨, 取50 μ L涂板; 消毒后的枝干从中间分开后剪成1 cm长的小段, 接入平板, 每处理重复3次, 于室温(23~25 ℃)下培养。定期观察分离平板, 根据菌落形态、颜色、凸起特征、边缘特征等挑取不同单菌落, 纯化后保存。统计分析不同地区植物不同部位内生细菌的分布情况。
1.3.2 银杏内生拮抗细菌菌株的筛选 采用对峙生长法, 测定所有分离菌株对番茄灰霉菌的拮抗作用。在PDA平板中央接入5 mm真菌菌丝块, 同时在距真菌块25 mm处的4个角点上分别接上分离菌株的菌苔, 平板直径90 mm, 28 ℃培养, 每处理重复3次, 以不接种分离菌株的真菌处理为对照。7 d后十字交叉法测量抑菌圈直径(mm)和对照处理菌落直径(mm), 并计算抑制率。
抑制率的计算公式:抑菌率=[(对照处理菌落直径-处理菌落直径)/对照处理菌落直径]× 100%
采用平板对峙生长法对常见的8种病原真菌进行广谱拮抗性测定, 方法同1.3.2。并在显微镜下观察生防菌株HZ-6-3拮抗部分病原真菌边缘菌丝的生长状态。
1.5.1 培养性状观察 将筛选出的拮抗细菌接种于NA平板上28 ℃恒温培养, 观察其菌落形态、颜色、质地等。
1.5.2 拮抗细菌的生理生化测定 参照《常见细菌系统鉴定手册》[18]中的方法, 对菌株HZ-6-3的需氧性、运动性、耐盐性、接触酶、氧化酶等生理生化指标进行测定。
1.5.3 基因序列分析鉴定 用Fast TIANamp Bacteria DNA Kit(天根, 北京)提取菌株HZ-6-3的全基因组DNA, 以细菌16S rRNA基因的通用引物27F(5'-AGAGTTTGATCCTGGCTCAG-3')和1492R(5'-CGGCTACC TTGTTACGAC-3') 对菌株的16S rRNA基因进行PCR扩增。25 μ L反应混合物在PCR热循环仪上进行扩增。PCR反应条件: 预变性94 ℃ 5 min; 变性94 ℃ 30 s, 退火56 ℃ 45 s, 延伸72 ℃ 1 min, 30个循环; 终延伸72 ℃ 10 min。利用引物gyrA-F (5'-CAGTCA GGAAATGCGTACGTCCTT-3')和gyrA-R(5'-CAAGGTAATGCTCCAGGCATTGCT-3')扩增gyrA基因。PCR反应条件: 预变性94 ℃ 5 min; 变性94 ℃ 1 min, 退火60 ℃ 1 min, 延伸72 ℃ 1 min, 30个循环; 终延伸72 ℃ 10 min。
PCR产物检测提纯并送到生工生物工程(上海)股份有限公司进行测序。测序结果在NCBI (www .ncbi .nlm.nih .gov)数据库中进行BLAST比对, 选取相似度超过95%的序列进行系统进化分析。序列先采用MEGA 6.0软件包中的ClustalW进行多重比对, 然后采用 Neighbour-joining(Kimura’ s 2-parameter 模型, bootstrap 1000)法构建系统发育树。菌株HZ-6-3的16S rRNA基因和gyrA基因序列提交NCBI数据库。
测定与拮抗作用相关的4种胞外酶(蛋白酶、淀粉酶、果胶酶和β -1, 3-葡聚糖酶)的活性。将培养48 h的生防菌株, 分别点接在4种检测培养基平板中心处, 每个处理重复3次。接菌后, 28 ℃恒温培养3 d, 用0.01%的刚果红溶液淹没β -1, 3-葡聚糖酶检测培养基15 min后, 如可见一个清晰的环状带产生, 说明该菌株产生β -1, 3-葡聚糖酶, 用革兰氏碘溶液淹没果胶酶检测培养基10 min后, 如可见一个清晰的环状带产生, 说明该菌株产生果胶酶, 其他酶检测培养基直接观察有无清晰的环状带产生。
采用叶面喷雾结合灌根的方法, 以番茄灰霉病菌(Botrytis cinerea)为供试病原菌, 试验设处理5个, 即1× 108, 1× 107和1× 106 CFU· mL-1, 以50%啶酰菌胺(WG, 巴斯夫欧洲公司)作为阳性对照, 清水作为空白对照, 测定该菌株对番茄灰霉病菌的预防效果和治疗效果。每处理10株, 重复3次。
菌株HZ-6-3发酵液的制备:将-80 ℃冰箱中超低温冷冻保存的菌株HZ-6-3取出, 接种在NA培养基平板上, 28 ℃活化培养24 h。以接种环挑取菌株菌落, 接入100 mL (500 mL三角瓶)的NA培养液中, 28 ℃, 180 r· min-1振荡培养24 h, 得菌株种子液。取所得种子液, 按2%接种量(2 mL)加入到100 mL (500 mL三角瓶)的NA培养液中, 28 ℃, 180 r· min-1振荡培养2 d, 得菌株发酵液。
番茄灰霉病菌孢子悬浮液的制备:在培养好的番茄灰霉病菌的PDA 平板中, 加入适量吐温80的蒸馏水, 轻轻振荡30 min, 将菌悬液倒出, 用血球计数板将分生孢子浓度调整为105 个· m
预防效果的测定方法:将稀释的拮抗细菌发酵液喷于植株, 以叶片上布满药液且不滴水为度, 并同时以每株50 mL处理液灌根。50%啶酰菌胺按照生产公司的使用说明剂量使用。处理后24 h喷接种番茄灰霉病菌孢子悬浮液于各处理植株, 于20~25 ℃下保湿, 处理后第7天调查发病情况, 按农药田间药效实验准则的标准进行病害分级, 并计算病情指数和防治效果。
分级标准, 0 级:无病症; 1 级:接种点出现轻微的病斑且不扩展, 病斑面积占叶片总面积的 10%以下; 2 级:病斑面积占叶片总面积的 20%以下; 3 级:坏死斑面积占叶片总面积的 30%以下, 接种点黄化面积占叶片总面积的 50%以下; 4 级:坏死斑面积占叶片总面积的 30%~60%; 5 级:坏死斑面积占叶片总面积的 60%以上。
病情指数=
防治效果=(对照病情指数-处理病情指数)/对照病情指数× 100%
治疗效果的测定:先将番茄灰霉病菌孢子悬浮液喷于接种番茄植株, 于20~25 ℃下保湿1~2 d后, 将拮抗细菌稀释发酵液喷于处理植株, 并同时以每株50 mL处理液灌根, 50%啶酰菌胺按照生产公司的使用说明剂量使用, 喷雾处理后第7天调查发病情况并计算病情指数和防治效果。
2.1.1 灰葡萄孢拮抗细菌的分离 从银杏茎、叶组织中共分离得到87株内生细菌菌株, 30株内生真菌菌株。甘肃兰州和陇南分别分离出内生菌49和68株, 占总分离数的41.88%和58.11%。由于内生细菌应用最普遍, 且抑菌能力最强, 并能够与寄主植物更好的共生, 亦可通过产生次生代谢产物促生和抵御病虫害, 因此本研究只选择内生细菌为研究对象。从叶片中分离出内生细菌46株, 占总分离出细菌数的52.87%, 茎中分离出41株, 占总分离出细菌数的47.13%(表1), 采用室内平板对峙生长法, 对上述细菌菌株对番茄灰霉病菌的拮抗作用进行筛选。初筛结果显示共有63株菌株对灰葡萄孢菌均有不同程度的拮抗作用, 挑选其中表现较好的19株细菌进行复筛。
| 表1 银杏内生菌分离结果 Table 1 The results of endophytes isolated from ginkgo biloba |
2.1.2 灰葡萄孢菌拮抗细菌的复筛 对初筛选出的19株内生拮抗细菌进行复筛, 结果表明对番茄灰霉病菌抑菌率均在60%以上 (图 1)。其中对番茄灰霉病菌抑菌率在70%以上的菌株有11株, 菌株HZ-6-3对病原菌抑制效果最明显, 平板拮抗活性最强且最稳定, 抑菌率为79.06%, 与其他各菌株有极显著差异。因此, 选择HZ-6-3进行下一步试验。
室内平板拮抗试验结果表明(图2、表2), 拮抗菌株HZ-6-3对8类病原真菌均具有不同程度的抑菌效果, 其抑菌率达58.75%~73.13%, 其中对棉花炭疽病菌的抑菌效果最好, 抑菌率为73.13%(图2I), 对大麦赤霉病菌的抑菌效果最差, 抑菌率为58.75%(图2F)。
| 表2 HZ-6-3对8种植物病原真菌生长的抑菌效果 Table 2 Antagonistic effects of HZ-6-3 to eight plant pathogenic fungi (%) |
植物病原真菌受到拮抗菌株HZ-6-3抑制后, 菌落边缘明显停止生长, 镜检对峙培养中抑菌带边缘菌丝的变化状况, 与对照菌落相比, 受到拮抗细菌抑制的病原菌出现菌丝生长扭曲, 变形, 菌丝变粗变短、或突然缢缩、细胞膨大等畸变(图3)。
2.4.1 培养性状的观察 HZ-6-3在NA培养基上, 菌落呈现圆形或近圆形, 边缘不整齐, 乳白色, 表面凹陷, 上生皱褶, 无光泽, 干燥。菌体短杆状, 芽孢内生, 革兰氏染色阳性(表3)。
| 表3 菌株HZ-6-3的生理生化特征 Table 3 Characteristics of strain HZ-6-3 |
2.4.2 生理生化特征测定 参照芽孢杆菌鉴定表中规定的相关测定项目, 对菌株HZ-6-3进行了生理生化主要指标测定(表3)。根据形态特征和生理生化特征, 将该菌株归于芽孢杆菌属(Bacillus)。
2.4.3 菌株HZ-6-3的分子鉴定 菌株 HZ-6-3的16S rRNA基因序列长度为1398 bp, gyrA基因序列长度为1039 bp, GenBank登录号分别为MH704744和MH704745。在NCBI数据库中BLAST比对分析发现菌株HZ-6-3的16S rRNA序列与解淀粉芽孢杆菌(B. amyloliquefaciens)、枯草芽孢杆菌(B. subtilis)、甲基营养型芽孢杆菌(B. methylotrophicus)和贝莱斯芽孢杆菌(B. velezensis)同属近缘种, 序列同源性达99%, 从构建的系统发育树(图4)中可以看出其与B. amyloliquefaciens strain Jxnuwx-1 CCTCC M 2014638、B. amyloliquefaciens strain AMY02、B. methylotrophicus strain Y-2、B. subtilis strain YS51、B. velezensis strain FZB42处在同一分支上, 无法明确菌株HZ-6-3的种的分类地位; 菌株HZ-6-3的gyrA基因序列与已知解淀粉芽孢杆菌PG12、LSC04和41B-1的gyrA基因序列同源性分别为99%, 系统发育树结果也显示(图5), 菌株HZ-6-3与以上解淀粉芽孢杆菌同属一分支, 可将菌株HZ-6-3鉴定为解淀粉芽孢杆菌。因此, 根据gyrA基因序列构建的系统发育树, 可将更接近的解淀粉芽孢杆菌和枯草芽孢杆菌清晰区分为 2个分支(图4和图5)。
将菌株接种在4种胞外酶检测培养基上, 结果(图6)显示, 拮抗菌HZ-6-3可以在蛋白酶、果胶酶、β -1, 3-葡聚糖酶、淀粉酶培养基的周围产生酶解圈, 表明该菌株在生长过程中能够产生分解以上各物质的酶类。
盆栽实验结果显示(表4), 菌株HZ-6-3对番茄灰霉病有较好的预防效果和防治效果, 且预防效果优于治疗效果, 随菌液浓度的增大, 效果均表现出递增的趋势。以原液(菌液浓度为1× 108 CFU· mL-1)施药7 d后, 该菌株对番茄灰霉病的预防效果达81.12%, 治疗效果为70.45%, 但仍没有阳性对照的效果好, 各处理的预防效果差异显著(P< 0.05); 将菌液浓度稀释10倍后, 治疗效果为67.52%, 与原液无显著性差异; 将菌液稀释100倍后, 预防效果为69.86%, 治疗效果为61.51%, 与原液和稀释10倍的菌液处理表现出显著性差异(P< 0.05)。
| 表4 拮抗菌株HZ-6-3对番茄灰霉病菌的盆栽防效试验 Table 4 The control efficiency of biocontrol strain HZ-6-3 against B. cinerea |
目前, 从银杏中分离获得内生真菌或活性物质抑制植物病原菌的研究已经有不少, 但关于银杏内生细菌的研究却相对较少。本试验从银杏的茎和叶中分离到一株对植物病原真菌拮抗谱较广、且抑菌效果较好的内生细菌菌株HZ-6-3, 胞外酶活性检测结果表明, 该菌株具有产生蛋白酶、果胶酶、β -1, 3-葡聚糖酶、淀粉酶的能力, 这些物质均与该菌株的拮抗活性密不可分, 如蛋白酶可抑制病原菌生长, β -1, 3-葡聚糖酶通过水解β -1, 3-糖苷键破坏真菌细胞壁等, 因此, HZ-6-3与番茄灰霉病菌对峙培养后, 镜检抑菌带边缘的菌丝, 致畸作用明显, 但到底是哪种拮抗物质发挥作用还未做研究。潘虹余等[19]研究了解淀粉芽孢杆菌B15发酵液对灰葡萄孢抑菌机理, 发现该菌株的拮抗物质种类较多; 刘超等[20]通过液相色谱分析解淀粉芽孢杆菌BA-26中的抗灰葡萄孢物质不是单一物质。因此, HZ-6-3的拮抗机制也可能是一种或多种物质共同作用的结果, 其抑制为下一步重点研究目标。
从两地采集的银杏样品中共分离得到117株内生菌, 陇南样品分出率高于兰州样品, 这可能与植株的生长环境、采集样品的时间有关系。研究表明, 植物内部的微生物种群数与该植株生长环境关系密切, 植物会根据不同的外界环境的变化来改变自身的内生菌种群数。另外, 内生微生物种群数与植株树龄可能也有一定的关系。植物会根据周围环境的变化相应的改变体内的微生物种群来适应环境, 这是长期进化形成的应答机制。陇南样品的树龄在30年左右, 而兰州的银杏树龄只有10年, 树龄越长, 这种机制变化应用越自如, 因此内生微生物种群的差别可能就有较大, 这与Asraful等[21]的研究结果相似。另外, 由表1看出, 从相同地点的植株样品的不同组织部位中分离得到的内生微生物也有所不同, 这也与以往的研究相符[22], 这可能是因为植物的不同组织的功能有所不同, 特定的内生微生物种群有自己特定的作用。
前期预试验中, 从87株内生细菌菌株中挑选长势较好、易于培养的菌株81株, 采用平板对峙法检测81株内生细菌菌株对12种病原真菌菌落生长的抑制情况。结果显示, 72株内生细菌对病原真菌有不同程度的拮抗能力, 占分离总株数的82.76%; 对2种以上病原菌有拮抗作用的菌株共有71株, 占分离内生细菌总株数的81.60%; 对5种及以上病原菌有拮抗作用的菌株共有65株, 占分离内生细菌总株数的74.71%, 占具有拮抗作用菌株数的80.25%。这说明, 银杏叶片中的内生细菌种群多样性丰富, 且大部分内生细菌菌株的广谱性和拮抗能力均较强, 这可能是由于内生菌与寄主植物银杏长期协同进化从而产生与寄主相同的抗菌物质。因此, 显示出银杏内生细菌可能在植物病害生物防治中具有巨大的开发应用潜力, 可为更多的生防研究提供很好的菌株资源。
应用16S rRNA基因序列对一些序列间相似度较高的同源性细菌种群区分困难, 本试验16S rDNA分析结果验证了该说法。正因为此, 本研究中的菌株 HZ-6-3出现了多种同源性较高的芽孢杆菌, 很难精确确定其分类地位。特异PCR技术可实现微生物物种甚至是亚种间的区分, 因此利用如gyrA[23]、gyrB[24]、rpoD[25]基因来区别芽孢杆菌的近缘种越来越普遍, 如Wang等[24]利用gyrB序列分析鉴定, 从种水平上区分枯草芽孢杆菌及其近缘种。本研究利用传统观察和分子水平检测相结合的方法, 利用gyrA基因序列将亲缘关系非常接近的解淀粉芽孢杆菌和枯草芽孢杆菌在系统发育树中明显地区分开, 证明细菌gyrA基因可以有效区分亲缘关系相近的细菌种群, 弥补16S r RNA基因序列的不足。
室内平板拮抗试验发现, 本研究筛选的解淀粉芽孢杆菌HZ-6-3具有广谱的抑菌活性, 除了对灰霉病菌有较好的抑制作用外, 还对常见的8种病原真菌也有较好的抑制作用。盆栽试验表明, 菌株HZ-6-3对番茄灰霉病的防治有良好效果, 且预防效果优于治疗效果, Klein等[26]研究结果显示, 芽孢杆菌及其代谢产物不但可以直接作用灰葡萄孢菌的生长繁殖, 并且能诱导寄主植物产生系统抗病, 这是由它的防病机制决定的。这一特点与杨利敏等[27]的研究结果相似, 用这一类菌株制剂防病, 发病前或发病初期是施药最佳时间, 充分发挥它们的预防效果, 尽早在环境中引入对病原菌的抑制因子, 从而增加寄主植物对病害的抗性, 较好地控制或减轻病害的发生。然而, 本研究盆栽试验结果也说明, 不管是治疗效果还是预防效果, 该菌株明显弱于阳性对照化学药剂50%啶酰菌胺, 这也说明拮抗微生物在田间应用的制约因素还有很多[28], 因此要将该菌株用于农业生产上防治植物病害还需做另外更深入的研究, 如明确拮抗物质及其作用机制、发酵试验、制剂研制等。
| [1] |
|
| [2] |
|
| [3] |
|
| [4] |
|
| [5] |
|
| [6] |
|
| [7] |
|
| [8] |
|
| [9] |
|
| [10] |
|
| [11] |
|
| [12] |
|
| [13] |
|
| [14] |
|
| [15] |
|
| [16] |
|
| [17] |
|
| [18] |
|
| [19] |
|
| [20] |
|
| [21] |
|
| [22] |
|
| [23] |
|
| [24] |
|
| [25] |
|
| [26] |
|
| [27] |
|
| [28] |
|